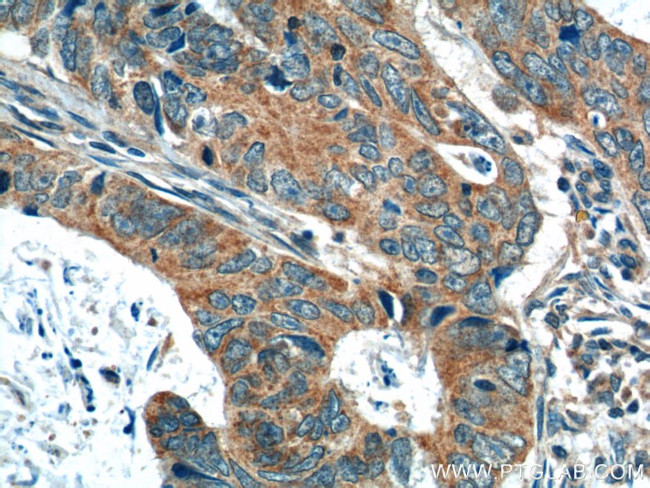
OSBPL3 Antibody in Immunohistochemistry (Paraffin) (IHC (P))

Search
Proteintech
OSBPL3 Polyclonal Antibody
{{$productOrderCtrl.translations['antibody.pdp.commerceCard.promotion.promotions']}}
{{$productOrderCtrl.translations['antibody.pdp.commerceCard.promotion.viewpromo']}}
{{$productOrderCtrl.translations['antibody.pdp.commerceCard.promotion.promocode']}}: {{promo.promoCode}} {{promo.promoTitle}} {{promo.promoDescription}}. {{$productOrderCtrl.translations['antibody.pdp.commerceCard.promotion.learnmore']}}
产品信息
12417-1-AP
种属反应
宿主/亚型
分类
类型
抗原
偶联物
形式
浓度
规格
纯化类型
保存液
内含物
保存条件
运输条件
产品详细信息
Immunogen sequence: MMSDEKNLG VSQKLVSPSR STSSCSSKQG SRQDSWEVVE GLRGEMNYTQ EPPVQKGFLL KKRKWPLKGW HKRFFYLDKG ILKYAKSQTD IEREKLHGCI DVGLSVMSVK KSSKCIDLDT EEHIYHLKVK SEEVFDEWVS KLRHHRMYRQ NEIAMFPHEV NHFFSGSTIT DSSSGVFDSI SSRKRSSISK QNLFQTGSNV SFSCGGETRV PLWLQSSEDM EKCSKDLAHC HAYLVEMSQL LQSMDVLHRT YSAPAINAIQ GGSFESPKKE KRSHRRWRSR AIGKDAKGTL QVPKPFSGPV RLHSSNPNLS TLDFGEEKNY SDGSETSSEF SKMQEDLCHI AHKVYFTLRS A (1-350 aa encoded by BC017731)
靶标信息
ZNF703 belongs to the Elbow/Noc family. It contains 1 C2H2-type zinc finger.ZNF703 may function as a transcriptional repressor.
仅用于科研。不用于诊断过程。未经明确授权不得转售。
生物信息学
蛋白别名: ORP-3; OSBP-related protein 3; OSBP3; oxysterol binding protein-like 3; Oxysterol-binding protein-related protein 3; Phosphoinositide transfer protein
基因别名: 1200014M06Rik; 6720421I08Rik; A530055M08; KIAA0704; ORP-3; ORP3; OSBP3; OSBPL3; RGD1564287
UniProt ID: (Human) Q9H4L5, (Mouse) Q9DBS9
Entrez Gene ID: (Human) 26031, (Rat) 362360, (Mouse) 71720